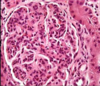
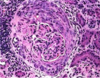

Pics for Terminology of the Glomerulus Flashcards
(10 cards)
What term descibes the patten of change in the glomeruli?
• What is the opposite effect called?

Diffuse disease involvment
Opposite of diffuse is focal shown below

How would you descibe the manner in which the disease has affected this glomeruli?
• what is the opposite of this?

segemental disease only involves parts of the glomerulus
global is shown below, it involves the entire glomerulus

What is wrong with this glomerulus?
proliferative damage can be seen here were there is increased numbers of cells and inflammation
what is shown here?

Glomerulus with membranous disease causing a thickened glomerular basement membrane
What disease process is seen here?

Membranoproliferative - combination of BOTH increased cell number, inflammation, and thickening of basement membrane
What is seen here?
• cells responsible?

crescentic glomerulonephritis - involves Bowman’s space
proliferating partietal epithelial cells and inflitrating macrophages cause this
What is shown here?

Necrotizing glomerulonephritis
What is shown here?
necrotizing AND organizing glomerulonephritis
What is shown here?

Glomerulosclerosis with fibrous scar replacing glomerulus
What is shown here?

segemental glomerulosclerosis scar has only replaced part of the tissue